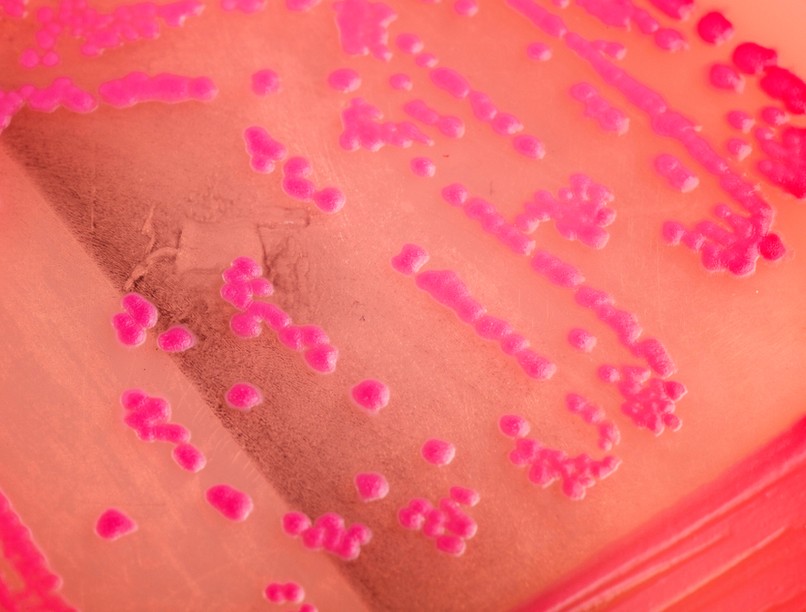
mikrobiológiai tenyésztés baktérium vírus vizsgálat leírás

A mikrobiológiai tenyésztés egy laboratóriumi vizsgálat, amelynek célja a szervezetben jelen lévő mikroorganizmusok, például baktériumok, gombák vagy ritkábban vírusok kimutatása és azonosítása.
Mi a mikrobiológiai tenyésztés, és mire használják?
A mikrobiológiai tenyésztés egy laboratóriumi vizsgálati módszer, amely során kórokozó mikroorganizmusokat (baktériumokat, gombákat vagy ritkán vírusokat) szaporítanak speciális táptalajokon. Ezt a technikát fertőzések diagnosztizálására alkalmazzák, például húgyúti, légúti, bőr- és seb-, illetve vérfertőzések esetén. Az eljárás segít meghatározni, hogy milyen mikroba okozza a fertőzést, és mely antibiotikumokkal lehet hatékonyan kezelni.
A vizsgálat során mintát vesznek a páciens testéből – például vért, vizeletet, nyálat, torokváladékot, sebváladékot vagy más testnedveket –, majd a mintát speciális táptalajokra helyezik, ahol a kórokozók megfelelő környezetben szaporodhatnak. Ezután a tenyésztett mikroorganizmusokat azonosítják, és meghatározzák az adott kórokozók érzékenységét az antibiotikumokkal szemben, ami segít a megfelelő kezelés kiválasztásában.
A baktériumtenyésztés során általában 24-48 óra alatt nőnek ki a baktériumok a táptalajon, míg a vírusok vagy gombák esetén hosszabb idő, akár több nap vagy hét is szükséges lehet a növekedésükhöz. A mikrobiológiai tenyésztés a fertőzések diagnosztizálásának egyik legfontosabb eszköze, amely lehetővé teszi, hogy pontosan megállapítsák a fertőzés forrását, és célzott kezelést indítsanak.
Hogyan zajlik a mikrobiológiai tenyésztés vizsgálat?
A mikrobiológiai tenyésztés egyszerű, de pontos mintavételt igényel, amely a fertőzés helyétől függően különböző módokon történhet:
1. Mintavétel
Az orvos vagy a laboratóriumi szakember a fertőzés jellegétől függően vesz mintát. Ez lehet:
- Torokváladék (torokgyulladás, mandulagyulladás gyanúja esetén),
- Vizelet (húgyúti fertőzés esetén),
- Vér (szisztémás fertőzés, szepszis esetén),
- Sebváladék (seb- vagy bőrfertőzések esetén),
- Köpet (légúti fertőzések esetén),
- Széklet (gyomor-bélrendszeri fertőzések esetén).
2. Tenyésztés
A mintát táptalajokra helyezik, amelyek megfelelő környezetet biztosítanak a baktériumok, vírusok vagy gombák növekedéséhez. A táptalajt inkubátorba helyezik, ahol optimális hőmérsékleten és nedvességtartalom mellett a kórokozók elszaporodnak. A baktériumtenyésztés általában 24-48 órát vesz igénybe, míg vírusok esetén több időre van szükség.
3. Azonosítás
Miután a mikroorganizmusok kinőttek a táptalajon, a laboratóriumban azonosítják őket különböző vizsgálatokkal, például mikroszkópos elemzéssel, biokémiai tesztekkel, vagy molekuláris módszerekkel (pl. PCR, DNS-analízis).
4. Antibiotikum-érzékenység tesztelése
Ha a fertőzést baktérium okozza, gyakran elvégzik az antibiotikum-érzékenységi tesztet is, amely meghatározza, hogy mely antibiotikumok hatásosak a kimutatott baktérium ellen. Ez a vizsgálat kritikus fontosságú a célzott antibiotikum-kezelés meghatározásához, különösen a rezisztens kórokozók (pl. MRSA) esetén.
Milyen betegségek esetén van szükség mikrobiológiai tenyésztésre?
A mikrobiológiai tenyésztés számos fertőzés diagnosztizálására szolgál, különösen azokban az esetekben, amikor fontos a kórokozó pontos azonosítása és a célzott kezelés kiválasztása. Az alábbiakban felsorolok néhány olyan betegséget és állapotot, amelyek esetén gyakran szükség van mikrobiológiai tenyésztésre:
Húgyúti fertőzések (UTI)
A húgyúti fertőzések során a baktériumok megtelepednek a húgyutakban, és gyulladást okoznak. A vizeletmintából végzett baktériumtenyésztés segít azonosítani a fertőzésért felelős kórokozót (például E. coli), és megmutatja, mely antibiotikumok hatékonyak a kezelésére.
Légúti fertőzések
A felső és alsó légúti fertőzések, például torokgyulladás, tüdőgyulladás, arcüreggyulladás esetén a torok- vagy köpetmintából végzett tenyésztés segít meghatározni, hogy vírusos vagy bakteriális fertőzésről van-e szó. Például a torokgyulladást okozó Streptococcus pyogenes baktérium tenyésztéssel azonosítható.
Szepszis
A szepszis egy életveszélyes állapot, amelyet a szervezet súlyos fertőzésre adott túlzott válasza okoz. A vérből végzett tenyésztés segít azonosítani a véráramba jutott kórokozókat, például baktériumokat (bakterémia), és lehetővé teszi az azonnali célzott antibiotikum-kezelés elindítását.
Seb- és bőrfertőzések
Nyílt sebek vagy műtéti hegek esetén a baktériumok bejuthatnak a sebbe, és fertőzést okozhatnak. A sebváladék tenyésztésével azonosíthatók a fertőzésért felelős baktériumok (pl. Staphylococcus aureus), ami segíthet a megfelelő antibiotikum kiválasztásában.
Gyomor-bélrendszeri fertőzések
Székletmintából végzett mikrobiológiai tenyésztés szükséges lehet olyan fertőző betegségek esetén, mint a szalmonellózis, a Campylobacter-fertőzés vagy a Clostridium difficile okozta hasmenés. A vizsgálat segít azonosítani a baktériumokat vagy vírusokat, amelyek a gyomor-bélrendszeri tüneteket okozzák.
Szexuális úton terjedő betegségek (STD-k)
A mikrobiológiai tenyésztés hasznos lehet bizonyos szexuális úton terjedő betegségek, például a gonorrhoea és a chlamydia kimutatásában. Ilyen esetekben a hüvelyváladékból vagy húgycsőváladékból vett mintát tenyésztik ki, hogy meghatározzák a fertőzést okozó kórokozót.
Vírusos fertőzések
Bár a vírusok tenyésztése nehezebb és időigényesebb, bizonyos vírusos fertőzések esetén is szükség lehet mikrobiológiai tenyésztésre. Például a herpeszvírusok, az influenza vagy más légúti vírusok tenyésztéssel vagy molekuláris módszerekkel azonosíthatók.
A mikrobiológiai tenyésztés előnyei
- Pontos diagnózis: a tenyésztés segít pontosan meghatározni, hogy melyik mikroorganizmus okozza a fertőzést, ami lehetővé teszi a célzott kezelés alkalmazását.
- Antibiotikum-érzékenységi teszt: a tenyésztés során végzett érzékenységi vizsgálat lehetővé teszi, hogy az orvos a leghatékonyabb antibiotikumot írja fel, csökkentve a felesleges gyógyszerhasználatot és az antibiotikum-rezisztencia kialakulásának esélyét.
- Fertőzésforrások felderítése: a tenyésztés segít a fertőzés forrásának megállapításában, például egy műtéti seb vagy húgyúti fertőzés esetén.
A mikrobiológiai tenyésztés korlátai
- Időigényes: a baktériumok és vírusok tenyésztése időigényes lehet, különösen, ha a kórokozó lassan növekszik. Ez késleltetheti a diagnózist és a kezelést.
- Hamis negatív eredmények: bizonyos esetekben a kórokozók nehezen tenyészthetők, vagy a minta nem tartalmaz elegendő mikroorganizmust, ami hamis negatív eredményhez vezethet.
- Specifikus körülmények szükségesek: a tenyésztés során a mikroorganizmusoknak megfelelő táptalajra és környezeti feltételekre van szükségük, különben nem mutathatók ki.
Gyakori kérdések a mikrobiológiai tenyésztésről
A mikrobiológiai tenyésztés vizsgálat alapvető fontosságú a bakteriális és vírusos fertőzések diagnosztizálásában, mivel lehetővé teszi a fertőzésért felelős kórokozók azonosítását és azok antibiotikum-érzékenységének meghatározását. A vizsgálat különösen fontos a húgyúti, légúti, véráram-, bőr- és gyomor-bélrendszeri fertőzések diagnosztizálásában, valamint a szexuális úton terjedő betegségek felderítésében. Bár a vizsgálat időigényes lehet, a tenyésztés pontos eredményei kulcsfontosságúak a megfelelő kezeléshez és a beteg gyógyulásához.
Milyen minták alkalmasak mikrobiológiai tenyésztésre?
A vizsgálat különböző típusú mintákból végezhető el, például:
- vizelet
- vér
- torok- és garattörlet
- sebváladék
- hüvelyváladék
- köpet
- széklet
- agy-gerincvelői folyadék (speciális esetekben)
A mintavétel módja és időzítése nagyban befolyásolja a vizsgálat pontosságát. Fontos, hogy a minta ne szennyeződjön a bőrfelszín vagy más külső tényezők miatt.
Mennyi idő alatt készül el a mikrobiológiai tenyésztés eredménye?
Az eredmény általában 24–72 óra alatt elkészül, mivel a kórokozók szaporodásához időre van szükség. Bizonyos baktériumok gyorsan nőnek, míg mások (például a gombák vagy a lassan növekvő baktériumok, mint a Mycobacterium tuberculosis) akár több hétig is tenyészthetők. Az antibiotikum-érzékenységi vizsgálatok további 1–2 napot vehetnek igénybe.
Mennyire megbízható a mikrobiológiai tenyésztés eredménye?
A mikrobiológiai tenyésztés az egyik legmegbízhatóbb módszer a fertőzések diagnosztizálására, azonban az eredményt számos tényező befolyásolhatja. Ha a mintavétel nem megfelelő (pl. szennyezett minta, helytelen tárolás), az álnegatív vagy álpozitív eredményt adhat. Bizonyos baktériumok nehezen tenyészthetők, ezért ha a klinikai tünetek alapján erős a fertőzés gyanúja, de a tenyésztés negatív, további vizsgálatok (pl. PCR, szerológiai tesztek) szükségesek.
Miért fontos az antibiotikum-érzékenységi vizsgálat?
Az antibiotikum-rezisztencia egyre gyakoribb probléma, ezért nem minden antibiotikum hatékony minden kórokozó ellen. Az érzékenységi vizsgálat megmutatja, hogy a kimutatott baktérium mely antibiotikumokkal szemben érzékeny vagy rezisztens. Ez segít az orvosnak a leghatékonyabb és legbiztonságosabb kezelést kiválasztani, minimalizálva a szükségtelen antibiotikum-használatot.
Szükséges-e előzetesen antibiotikumot szedni a tenyésztés előtt?
Ha a beteg már antibiotikumot szed, az befolyásolhatja a vizsgálat eredményét, mert a kórokozók elpusztulhatnak vagy csökkenhet a számuk, így nem tenyésznek ki a táptalajon. Ha lehetséges, az antibiotikum-kezelés megkezdése előtt ajánlott a mintavétel. Ha a beteg már szed antibiotikumot, az orvos mérlegelheti a kezelés szüneteltetését vagy más diagnosztikai módszerek alkalmazását.
Hogyan kell előkészülni a mintavételre?
A minta típusától függően az előkészítés eltérő lehet:
- Vizelet: A reggeli első vizeletmintát középsugaras technikával kell venni, azaz az első pár millilitert ki kell engedni, majd a mintát egy steril tartályba kell gyűjteni.
- Torokváladék: A mintavétel előtt nem szabad enni, inni vagy fogat mosni.
- Széklet: A mintavételhez tiszta, szennyeződésektől mentes mintát kell biztosítani.
- Vér: A vérvételhez nem szükséges speciális előkészület, de éhgyomorra javasolt az elvégzése bizonyos esetekben.
Az orvos vagy a laboratórium részletes útmutatást adhat az adott mintavételi eljárásról.
Milyen kockázatai vannak a mikrobiológiai tenyésztésnek?
A mintavételi eljárások többsége fájdalommentes és kockázatmentes, de egyes esetekben (pl. vérvétel, gerinccsapolás) kisebb kellemetlenségek, fájdalom vagy ritkán fertőzés léphet fel. A helyesen végzett mintavétel minimalizálja a kockázatokat.
Mi a teendő, ha a tenyésztés eredménye pozitív?
Ha a vizsgálat kórokozót mutat ki, az orvos a megfelelő antibiotikumot vagy egyéb kezelést írhat fel az antibiotikum-érzékenységi vizsgálat alapján. Fontos, hogy a beteg az előírt kezelést pontosan betartsa, és ne hagyja félbe idő előtt az antibiotikum-kúrát, mert ez a baktériumok rezisztenciájához vezethet.
Lehet-e negatív a tenyésztés eredménye fertőzés esetén?
Igen, előfordulhat, hogy egy betegnek tünetei vannak, de a tenyésztés negatív eredményt ad. Ennek több oka lehet, például:
- A mintavétel nem megfelelő időben történt.
- Az antibiotikum-kezelés elpusztította a kórokozókat.
- A fertőzést olyan mikroorganizmus okozza, amely nehezen vagy egyáltalán nem tenyészthető (pl. vírusok, intracelluláris baktériumok).
- Ebben az esetben az orvos egyéb diagnosztikai módszereket (pl. PCR, szerológia) alkalmazhat a pontosabb diagnózis érdekében.
Veszettség esetén szükség lehet mikrobiológiai vizsgálatra?
Igen, veszettség gyanúja esetén szükség lehet mikrobiológiai vizsgálatra, különösen a diagnózis megerősítésére. A veszettséget a Rabies-vírus okozza, amely az idegrendszert támadja meg, ezért a laboratóriumi vizsgálatok segítenek a fertőzés igazolásában. Élő ember esetében a diagnózist nyál-, bőrbiopszia-, könny- vagy agyvízminta PCR-vizsgálatával lehet megerősíteni, amely kimutatja a vírus RNS-ét.
Szepszis esetén szükség lehet mikrobiológiai vizsgálatra?
Szepszis esetén mindenképpen szükség van mikrobiológiai vizsgálatra, mivel ez segít azonosítani a fertőzést kiváltó kórokozót. A legfontosabb ilyen vizsgálat a vértenyésztés, amelyet lehetőleg antibiotikum adása előtt kell elvégezni. Emellett a fertőzés feltételezett forrásától függően további minták például vizelet-, köpet- vagy sebváladék-tenyésztés is indokoltak lehetnek. A mikrobiológiai eredmények alapján az orvos célzott antibiotikum-kezelést tud beállítani, ami jelentősen növeli a gyógyulás esélyét.
Trichomonas-fertőzés esetén szükség lehet mikrobiológiai vizsgálatra?
Igen, Trichomonas-fertőzés esetén szükség lehet mikrobiológiai vizsgálatra a pontos diagnózis felállításához. A Trichomonas vaginalis egy egysejtű parazita, amely főként nemi úton terjed, és nőknél hüvelygyulladást, férfiaknál húgycsőgyulladást okozhat. A fertőzés igazolásához a leggyakrabban hüvelyváladékból vagy húgycsőváladékból vett minta mikroszkópos vizsgálatát végzik, ahol a mozgó kórokozók közvetlenül láthatók. Emellett elérhetők tenyésztéses, antigénkimutatásos vagy PCR-alapú vizsgálatok is, amelyek pontosabban és érzékenyebben mutatják ki a kórokozót.
Az utazók hasmenése esetén szükség lehet mikrobiológiai vizsgálatra?
Igen, az utazók hasmenése esetén gyakran szükség lehet mikrobiológiai vizsgálatra, hogy pontosan azonosítani lehessen a fertőzést okozó kórokozót. A vizsgálat segít megkülönböztetni a bakteriális, vírusos vagy parazitás eredetet, és meghatározni, szükséges-e célzott antibiotikum- vagy antiparazitás terápia.
A nyakcsatorna-gyulladás esetén szükség lehet mikrobiológiai vizsgálatra?
Igen, a nyakcsatorna-gyulladás esetén gyakran szükség van mikrobiológiai vizsgálatra. A vizsgálat célja, hogy meghatározzák a gyulladást okozó kórokozót, ami lehet bakteriális (pl. Chlamydia trachomatis, Neisseria gonorrhoeae), vírusos vagy gombás eredetű. A mintavétel általában a méhnyakból vett váladékból történik, amelyet laboratóriumban tenyésztéssel, PCR-vizsgálattal vagy antigén-detektálással elemeznek. A mikrobiológiai vizsgálat alapvető a célzott antibiotikum vagy egyéb terápia megválasztásához, és segít a fertőzés kiújulásának megelőzésében is.
A vesemedence-gyulladás esetén szükség lehet mikrobiológiai vizsgálatra?
Igen, vesemedence-gyulladás esetén gyakran szükség van mikrobiológiai vizsgálatra. A vizelettenyésztés segít azonosítani a kórokozót, amely a fertőzést okozza. Ennek alapján célzott antibiotikum-kezelés választható, ami hatékonyabb a empirikus terápiánál. Súlyosabb esetekben vagy szövődmény gyanújakor vértenyésztésre is sor kerülhet. A mikrobiológiai vizsgálat csökkenti a kezelés sikertelenségének és a szövődmények kialakulásának kockázatát.
Felhasznált források:
- Mayo Clinic - Bacterial Culture Test
- Cleveland Clinic - Microbiological Culture
- American Society for Microbiology - Clinical Microbiology and Infectious Diseases
- National Institutes of Health - Microbiology Test: Culture and Sensitivity
Kövesse az Egészségkalauz cikkeit a Google Hírek-ben, a Facebook-on, az Instagramon vagy a X-en,Tiktok-on is!